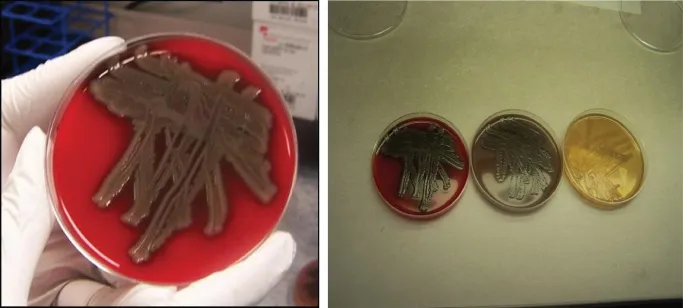
c01f002

- English
- ePUB (mobile friendly)
- Available on iOS & Android
Cases in Clinical Infectious Disease Practice
About this book
In the era of cost cutting and lack of adequate health insurance for many patients, clinical skills and time spent with patients are not adequately compensated. Yet, these dwindling and underpaid skills – good history taking, observation of and listening to patients, and physical examination of patients – remain very essential to making and reaching a complete and accurate diagnosis. Expensive laboratory and imaging diagnostics while very relevant, should not replace these age-old skills that have served to enhance and maintain the doctor-patient relationship and human connection, a connection that is often necessary for healing.
Cases in Clinical Infectious Disease Practice uses case studies to illustrate how the infectious disease clinician processes and integrates data to arrive at a diagnosis. This type of hands-on approach, invaluable in training programs, is utilized to take the reader through initial patient encounter, through the history and physical examination, to simple laboratory findings and stains, to a final diagnosis, in a way that is easily accessible to clinicians, students, and laboratory personnel working with clinical specimens.
- Appeals to practitioners of all levels, with focus on patients with common problems or complications of common infections without heavy technical language
- Emphasizes basic clinical skills including history taking, observation, epidemiology, and physical exam, as well as simple laboratory tests, explaining how they lead to a reasonable diagnosis
- Presents cases seen first-hand within the community setting, reflective of cases or situations a resident or student is likely to encounter in the real world after training
Cases in Clinical Infectious Disease Practice is an essential resource for clinicians, graduate and medical school students, and others conducting medical and clinical microbiology or infectious disease research on real patients.
Frequently asked questions
- Essential is ideal for learners and professionals who enjoy exploring a wide range of subjects. Access the Essential Library with 800,000+ trusted titles and best-sellers across business, personal growth, and the humanities. Includes unlimited reading time and Standard Read Aloud voice.
- Complete: Perfect for advanced learners and researchers needing full, unrestricted access. Unlock 1.4M+ books across hundreds of subjects, including academic and specialized titles. The Complete Plan also includes advanced features like Premium Read Aloud and Research Assistant.
Please note we cannot support devices running on iOS 13 and Android 7 or earlier. Learn more about using the app.
Information
Chapter 1
Skin and Soft Tissue Infections
Case 1.1 Soft tissue infection following traumatic aquatic exposure
- What are the likely organisms in this patient (differential diagnoses) and why?

- What is your new diagnosis?
- What were the clues to the diagnosis?

Case discussion
Differential diagnosis
- Final diagnosis: Aeromonas hydrophila
| Organisms | Exposure | Clinical syndromes |
| Aeromonas spp* | Fresh water | Rapidly developing infection associated with fever; sepsis |
| Edwardsiella tarda* | Fresh water | Cellulitis, occasionally fulminant infection with bacteremia |
| Erysipelothrix rhusiopathiae | Puncture wounds from shrimp, crabs, and fish | Indolent localized cutaneous eruption; erysipeloid |
| Vibrio vulnificus* | Salt or brackish water | Rapidly progressive necrotizing infection; bullous cellulitis; sepsis |
| Mycobacterium marinum | Salt or fresh water including fish tanks | Indolent in... |
Table of contents
- Cover
- Title Page
- Copyright
- Table of Contents
- Table of Normal Laboratory Values*
- About the Author
- Dedication
- Acknowledgments
- Preface
- Introduction
- How the book should be used and understood
- Chapter 1: Skin and Soft Tissue Infections
- Chapter 2: Fever of Unknown Origin and Drug-Induced Fever
- Chapter 3: Dermatologic Manifestations of Infectious and Non-infectious Diseases
- Chapter 4: Diseases Acquired Through Close Contact with Animals
- Chapter 5: Travel-associated Blood-borne Parasitic Infection
- Chapter 6: Gulf Coast Tick Rash Illness*
- Chapter 7: Infectious Diseases Associated with Trauma and Outdoor Activities
- Chapter 8: Acute and Chronic Subcutaneous Fungal Infections
- Chapter 9: Endocarditis with Unusual Organisms or Characteristics
- Chapter 10: Severe Systemic Fungal and Other Infections in AIDS Patients
- Chapter 11: Toxic Manifestations of Infectious and Non-infectious Diseases
- Chapter 12: Skin and Soft Tissue Infections Seen Post Hurricane Katrina in 2005
- Chapter 13: Other Miscellaneous Infections
- Index
- End User License Agreement